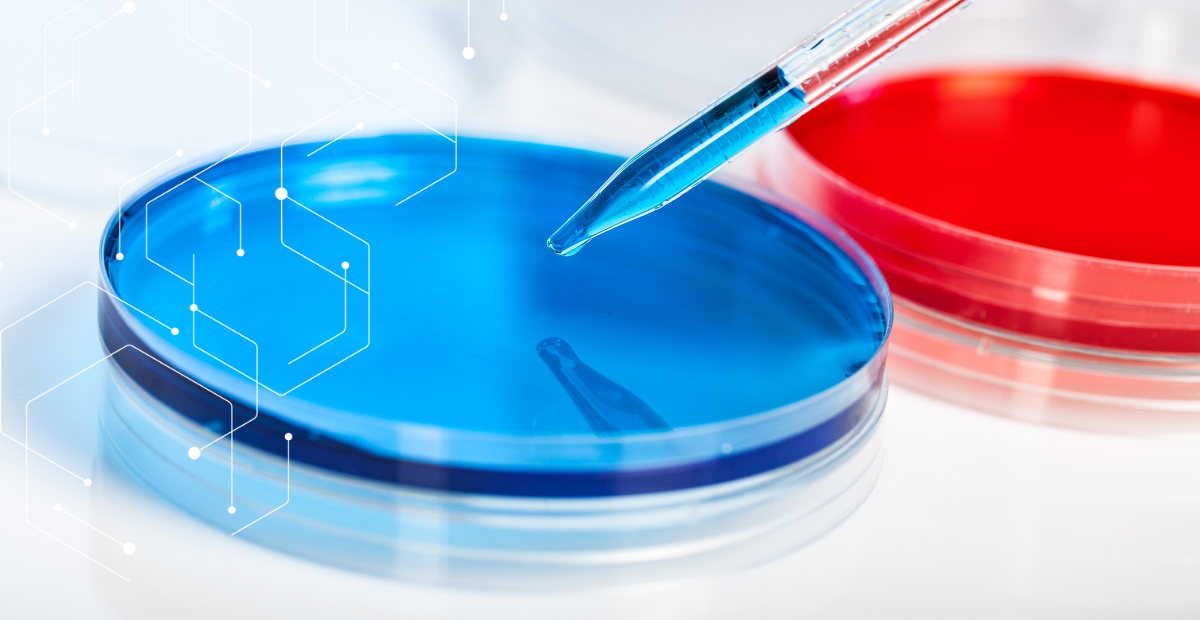

USP <797> Q&A: Cleanroom Requirements
In our USP <797> Q&A Series, we’ve mentioned cleanrooms a few times but haven’t gone too deeply into the topic.... Read more.

USP <797> Q&A: Sampling Pass-Throughs
In this series of Q&A posts, we’re answering questions from customers about USP <797> compliance. Some of these are common... Read more.

USP <797> Q&A: Do I need to have a microbiologist on staff?
If you have questions about how to comply with the latest revisions to USP <797>, you’re not alone. Even though... Read more.

USP <797> Compliance: It’s as Easy as A,B,C…1,2,3. Or is it?
Aspergillus, Bacillus, and Cladosporium – The Importance of Genus Identification The revised USP <797> standards for compounded sterile preparations (CSPs)... Read more.

USP <797> Personnel Competency Q&A
On September 18, Dr. Michael Berg, Technical Director Pace® Building Sciences, and Rhonda Lintner, Pace® Account Executive, presented a webinar... Read more.

Demonstrating USP <797> Surface Sampling Competency
In 2023, the USP <797> standard for compounded sterile preparations was significantly revised to improve patient safety. Not only are... Read more.
USP <797> FAQs: Media Kits
Lately, the Pace® microbiology team has been fielding a lot of questions on how to interpret and implement different aspects of... Read more.

10 Tips for Proper Shipping of USP <797> Samples
The 2023 revisions to USP <797> increase compliance requirements for compounding pharmacies. Following proper handling and shipping procedures for lab... Read more.
